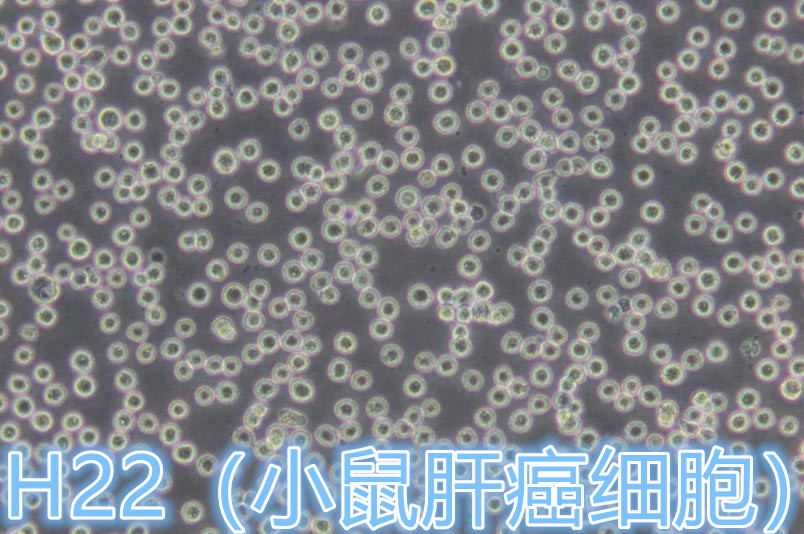

细胞名称:H22(小鼠肝癌细胞)
产品货号:YCL-0341
培养条件:RPMI-1640+10% FBS+1% P/S
生长特性:悬浮
细胞形态:淋巴母细胞样
产品规格:1×10
6cells/T25培养瓶

| 产品货号 | 细胞名称 | 中文名称 | 生长特性 | 细胞形态 | 产品规格 |
| YCL-0105 | Hepa 1-6 | 小鼠肝癌细胞 | 贴壁 | 上皮细胞样 | 1×106cells/T25培养瓶 |
| YCL-0341 | H22 | 小鼠肝癌细胞 | 悬浮 | 淋巴母细胞样 | 1×106cells/T25培养瓶 |
H22(小鼠肝癌细胞)在发货前进行质检:1、细胞存种的活性检测。
2、细菌、真菌、霉菌污染物镜检。
3、衣原体、支原体检测。
H22(小鼠肝癌细胞)质量保证及售后:1、运输过程中细胞出现污染和状态不好,免费重新发货。细胞经鉴定与承诺不符,无条件退款。
2、实验过程中若确定是客户本身问题,需支付物流和耗材费用,重新发货。其他根据情况灵活处理。
3、客户实验过程中,可提供相应技术指导。
武汉益普生物科技有限公司提供细胞株(人源细胞系均通过STR鉴定)、原代细胞(原代细胞免费提供免疫荧光/免疫组化鉴定报告,提供原代细胞分离报告)、蛋白、ELISA试剂盒、抗体、基因、质粒、生物芯片、细胞培养试剂等产品,多数产品货期在1-3天内发货,一周内到货(因细胞系冻存后复苏,需对细胞进行1-2代传代调整,期间进行微生物检测,货期为一周左右;因原代细胞培养的步骤是:新鲜组织取材→分离→培养,期间进行微生物检测,货期为3周左右)。低(常)温运输,货期短,快捷便利。我们为研究者们提供免费的专业的售前售中售后服务,为您的实验保驾护航。
用户须知:
1.关于货期:除细胞及定制产品外,承诺货期为1周内到(节假日顺延),大多数产品1-3天内发货。
2.关于订购:为了保证您的权益,下单前务必联系我司客户服务热线,确认产品质量保证内容,并获得后续全程售后服务保障全部内容。下单后非厂家特殊异常原因不能撤单。
3.如遇实验不良,需要提供实验数据,经技术部门分析为“产品质量不良”,我司将直接办理退款,无需退货。
联系人:田经理
电 话:13657268723(微信同号)
Q Q:344115770
座 机:027-87638958
邮 箱:344115770@qq.com
网 站:www.eproll.com(可点击企业网站链接)
地 址:武汉市洪山区狮子山街特一号华中农业大学天惠生物科技孵化器天惠楼221、223室